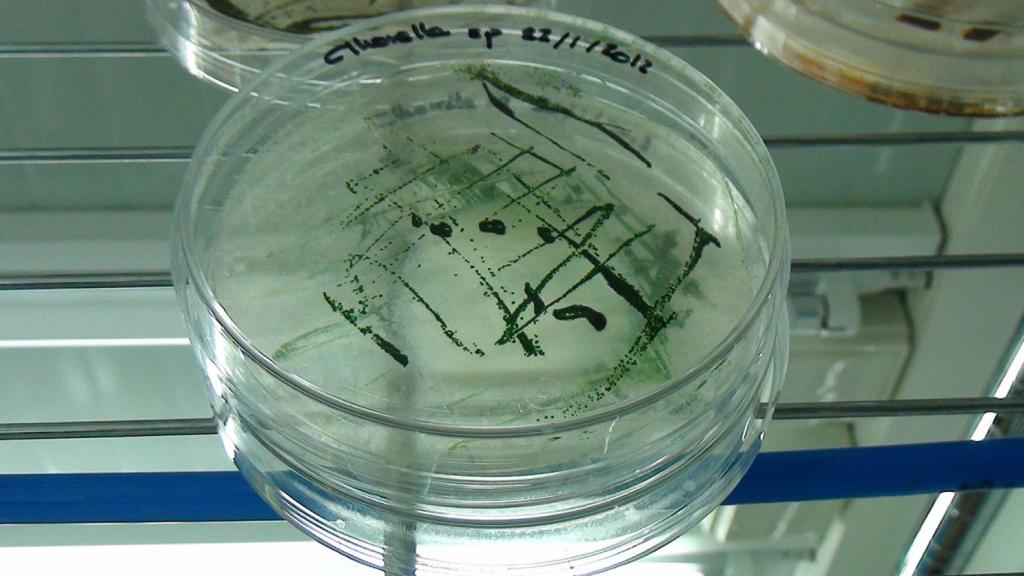
La española AlgaEnergy trabaja con cientos de tipos de microalgas

La española AlgaEnergy trabaja con cientos de tipos de microalgas
Microalgas, el maná que se cultiva a escala industrial
Estos organismos presentan nutrientes y un elevado contenido proteíco para enriquecer la dieta humana, además de bioestimular los cultivos para fortalecerlosrn
Existen más de 60.000 tipos de microalgas distintas, omnipresentes en todos los reinos de la naturaleza, salvo en el animal. Cuando aparecieron hace miles de millones de años, empezaron a generar la atmósfera rica en oxígeno que todavía disfrutamos. "Capturan el CO2 por biofijación, ya que lo utilizan como principal nutriente. Evitan la emisión de hasta dos kilos de dióxido de carbono por cada kilo de biomasa producido", indica Jorge Zapardiel, del departamento técnico-comercial de AlgaEnergy, una empresa española que cultiva masivamente microalgas en fotobiorreactores.
Paseamos con Jorge por un pasillo al aire, escoltados por fotobiorreactores verticales planos donde se cultivan microalgas a nivel industrial en la planta de 10.000 metros cuadrados que AlgaEnergy tiene en Arcos de la Frontera (Cádiz).
"Su variedad y riqueza bioquímica viene a ser una caja de herramientas inmensa para desarrollar aplicaciones comerciales en todo tipo de sectores. Trabajamos con cientos de microalgas seleccionadas a nivel de laboratorio y con varias decenas a nivel comercial, algunas de las que son todavía generalmente desconocidas, incluso en ámbitos experimentados", comenta. El conocimiento y las distintas tecnologías que dispone AlgaEnergy a nivel industrial, aprieta la clave: escalar el cultivo.
Ingrediente funcional
Las microalgas tienen una gran cantidad de pigmentos y carotenoides antioxidantes, polisacáridos, vitaminas, carbohidratos o proteína. Y son fuente muy rica en ácidos grasos Omega-3. Se pueden incorporar a componentes como alimentos funcionales en pastas o confitería, e incluso carne y derivados cárnicos, enriquecidos con Omega-3. Las macroalgas se destinan a espesantes de ciertos alimentos como gelatinas.
En los lineales es perenne el arándano. Una pequeña baya con gran contenido en antioxidantes se cuela entre las preferencias de los consumidores de lo healthy. "Quieren tener arándanos todo el año", exclama Fernando González Tirado, coordinador de la calidad de Fruta de Andalucía, que agrupa a productores de berries y fresas en Lucena del Puerto (Huelva). Entre Chile, España y los países de Centroeuropa y escandinavos se disputan el mercado. El reto es la calidad y aquí se apunta fuerte. Las microalgas tienen la culpa y mucho.
"Este arbusto tiene un sistema radicular muy delicado y los bioestimulantes agrícolas generan con vigor raíces nuevas", afirma González. AgriAlgae es una gama de estos productos destinada también a combatir el estrés de la planta durante todo el verano y a incentivar el verdor gracias al zinc y manganeso que enriquecen el bioestimulante. "La flor y el fruto salen ganando también por su uso", añade este técnico andaluz.
Fases del cultivo
Su primera fase consiste en generar células jóvenes de las estirpes seleccionadas. En esta etapa inicial, se mantiene y se genera un número de células en laboratorio, en cantidad y calidad adecuadas para disponer de concentraciones celulares o volúmenes de inóculo apropiados que permitan arrancar cultivos de mayor escala.
Tras esta etapa, el cultivo intensivo y sostenible de microalgas se desarrolla en los fotobiorreactores, unos tubos que están específicamente diseñados en geometría, material y tecnología para cada microalga. "Los principales parámetros a controlar durante este desarrollo son la radiación solar, la temperatura, el pH, el medio de cultivo con los nutrientes adecuados en función de la especie de microalga, el modo de operación, la tasa de dilución, el oxígeno disuelto, la agitación, etc.", enumera Zapardiel.
La clave está en que si se controlan estos parámetros de manera continua y se mantiene un rango óptimo de concentración de células en las condiciones adecuadas, se puede alargar la fase de cultivo durante un periodo de muchos meses, en el que se cosecha biomasa todos los días.
No todas son iguales
Existen muchas diferencias entre macroalgas y microalgas. "Tantas que, si no tuvieran un nombre similar, nadie las compararía, pues en la mayoría de los casos ni siquiera comparten el mismo reino de la naturaleza, aunque las microalgas sean las precursoras de las macroalgas", señala el técnico-comercial de AlgaEnergy.
Primero, las macroalgas se recolectan en el medio marino, unas de los mares del Sur (Ecklonia maxima), otras de los del Norte (Ascophyllum nodosum) y la calidad de los lotes es heterogénea. Las propiedades de microalgas, al cultivarse en fotobiorreactores, están homogeneizadas.
Las microalgas son seres unicelulares. En una sola célula han de tener todas las herramientas que puedan necesitar para reproducirse, para asimilar nutrientes, para cambios climatológicos, cambios de entorno o todo tipo de estrés. "Por ello, una célula de microalga, que es autónoma e independiente, es mucho más rica que una célula de macroalga. Esto se traduce, por ejemplo, en que las macroalgas tienen alrededor de un 5-9% de proteínas y las microalgas llegan al 70%, además con todos los aminoácidos esenciales", justifica.
Las microalgas son muy ricas en los ácidos grasos Omega-3, fuente original para los peces y moluscos. "En agricultura, destaca su gran contenido en fitohormonas fundamentales para el desarrollo de cualquier vegetal. Si bien las macroalgas tienen también fitohormonas, su contenido en las microalgas es muy superior".
De cosmética a biocombustible
AlgaEnergy se funda para canalizar el legado del conocimiento sobre microalgas. Hace 10 años se incorpora el profesor Miguel García Guerrero y se establecen acuerdos con el CSIC y varias universidades españolas. Hoy, la empresa es capaz de desarrollar una gama de bioestimulantes agrícolas y áreas verdes, biomasa para acuicultura, ingredientes funcionales para alimentación humana, aditivos para piensos animales, compuestos para cosmética y biocombustibles de cuarta generación.



